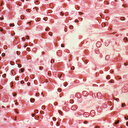

Son günlerde değişen mevsimle beraber çok sayıda adenovirüslere bağlı kerato-konjonktivit vakaları arttı. Medipol Mega Üniversite Hastanesi Göz Hastalıkları Bölümü’nden Dr. Öğr. Üyesi Cafer Tanrıverdi, adenovirüslerin Kovid-19 kadar hızlı yayılabildiğini belirterek, "Enfekte bireyden tüm aile fertlerine bulaşabiliyor. Bu hastalıktan korunmak için alınması gereken önlemler diğer tüm bulaşıcı hastalıklar ile benzerdir. Farklı olarak adenovirüslerin daha çok temasla bulaştığını düşünüyoruz. Bu nedenle hijyen kurallarına riayet edilmesi, kişisel eşyaların ortak kullanılmaması ve sık el yıkanması bu hastalıktan korunmak için özellikle gereklidir” ifadelerini kullandı.
Medipol Mega Üniversite Hastanesi Göz Hastalıkları Bölümü’nden Dr. Öğr. Üyesi Cafer Tanrıverdi, son günlerde değişen mevsimle beraber çok sayıda adenovirüslere bağlı kerato-konjonktivit vakalarının artığını bildirdi.
Dönem dönem salgınlar yapan adenovirüslerin ciddi işgücü kaybına da yol açtığını ifade eden Tanrıverdi, hastalığın sıklıkla karşılaşılan ilk bulgularını şöyle aktardı:
Tanrıverdi, hastalığın ilk semptomları ile karşılaşıldığı anda hekime başvurulması gerektiğine dikkati çekerek, “Adenovirüsler gözün önünde yer alan ve kornea olarak adlandırılan saydam tabakada görmeyi azaltabilen ve tedavisi oldukça güç lekelenmelere yol açabiliyor. Bu durumun tedavisi bazen aylar hatta yıllar alabilir.” uyarısında bulundu.
Temasla bulaşıyor, hızlı yayılıyor
- Tanrıverdi, adenovirüsler de Kovid-19 kadar hızlı yayılabildiğini, enfekte bireyden tüm aile fertlerine bulaşabildiğini aktararak, "Bu hastalıktan korunmak için alınması gereken önlemler diğer tüm bulaşıcı hastalıklar ile benzerdir. Farklı olarak adenovirüslerin daha çok temasla bulaştığını düşünüyoruz. Bu nedenle hijyen kurallarına riayet edilmesi, kişisel eşyaların ortak kullanılmaması ve sık el yıkanması bu hastalıktan korunmak için özellikle gereklidir.” değerlendirmesinde bulundu.
Hastaların bu dönemde yaşam kalitesinin oldukça azaldığını da belirten Tanrıverdi, "Tedavide uzun süreli göz damlası kullanılması gerekiyor. Ayrıca bu hastalığın en az hasarla geçirilmesi ve diğer aile fertlerinin korunması için hasta kişinin erken dönemde antiviral göz damlasına başlaması ve hastaların hastalık hakkında bilgilendirilmesi oldukça önemlidir.” ifadelerini kullandı.